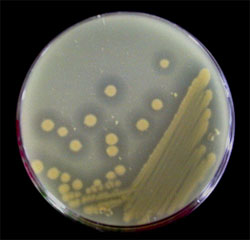

森林は地球環境を維持し、再生可能な資源を提供する人類にとって欠くことのできない環境である。森林環境中には様々な森林性昆虫が生息し、森林環境中の物質循環において重要な役割を果たしている。特にカブトムシをはじめとする鞘翅目甲虫類は、特定の樹種に生息し、生木・枯木・腐葉土と様々な食性を示す。この多様な食性を可能にしているのは、消化を助け栄養素を供給する微生物叢が存在するからと考えられ、その研究は、昆虫が環境中の物質循環に与える影響を理解し、昆虫を介した環境中における微生物動態の理解にも繋がると考えられる。また、未利用植物資源の有効利用に活用可能な酵素群をもつ重要な遺伝子資源として産業への応用も期待される。
カブトムシ(Trypoxylus dichotoma)は東アジア温帯の落葉広葉樹林や日本の里山のような人工林に生息する代表的な鞘翅目甲虫で、その幼虫は林床に発達する腐葉土に棲息し腐食性であるが、腸内微生物に関する報告はあまりない。本研究では、カブトムシ幼虫を主な材料とし、その腸内に存在する各種多糖類分解酵素を検索すると共に、腸内細菌叢を培養法と非培養法を組み合わせて解明することを目的としている。
カブトムシ幼虫の消化管は前腸、中腸、後腸の3部位からなり、その重量は体重の50%近くを占める。これまでの研究で、カブトムシ幼虫腸内はpH10前後のアルカリ性であり、植物細胞壁のヘミセルロース成分でキシリトールの原料となるキシランの分解活性が高いことを見いだした。また、培養法を用いることにより腸内には好気的アルカリ条件下で生育する菌が周囲よりも10倍から100倍多く存在し、優占する属が培地のpHや炭素源(グルコースやキシラン)で大きく異なることを示した。そこで、キシランを炭素源としたアルカリ性培地を用いてキシラン分解菌の探索を試みたところ、後腸より強いキシラン分解活性を有するBacillus属細菌を得ることに成功した。この菌の生産するキシラナーゼ、キシロシダーゼ活性について検討を加えた結果、カブトムシ幼虫腸内のpHでも活性を維持しキシランの消化分解に関与している可能性を示唆する結果を得たことから、より強力なキシラン分解活性を示す細菌の探索を続けている。
また、非培養法ではPCR-DGGE法を用いてカブトムシ幼虫腸内容物から抽出したDNAの解析を進めている。これまでのところ、16SrRNA遺伝子のV3領域を用いた解析の結果、カブトムシ幼虫腸内には、非常に多くの種類の細菌が存在する可能性が示され、その中から、優占的に存在する細菌の検索を進めている。
カブトムシは最も一般的な昆虫として、誰でも知っている森林性甲虫であるが、その生態系における役割に関しては明らかでない点が多く、本研究により、昆虫腸管内の微生物叢解析の手法を確立し、より多くの森林性甲虫類に適用することにより、森林環境における微生物動態を明らかにし、森林環境の保全に役立てることが出来ると考えている。
|
|
カブトムシ幼虫後腸から単離された好アルカリ性のBacillus属キシラン分解菌
白濁したアルカリ性キシラン寒天培地にキシラン分解菌を植菌すると菌から生産されたキシラン分解酵素の作用によりコロニーの周囲に透明なゾーンが形成される。 |
|
|
|